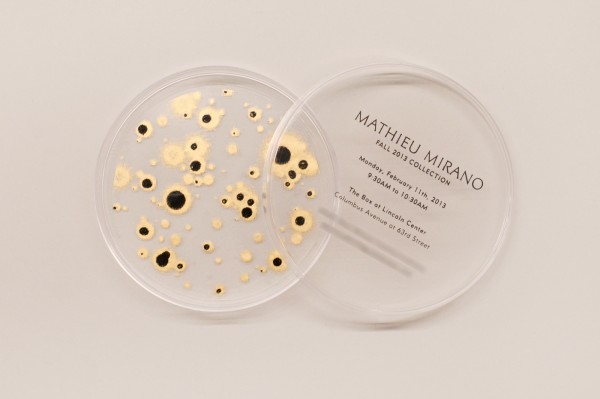

What I wouldn’t give to be packing my bags and boarding a plane to New York Fashion Week today. I’d push the cold weather to the back of my mind and focus on the amazing fashion that’s displayed over the next seven days. My glimpse into this year’s events will be through twitter, instagram and the new vine app of fashion bloggers and magazines covering the shows, parties and street style. It’s the next best thing to being a part of the action, right? On the positive side, at least I’ll be inside, warm and enjoying the shows without the pressure of 5 inch heels.
(although lets be honest, I’d gladly be out in the cold and rocking massive heels to be in NYC)
This collection of invites that refinery 29 put together shows some of the chicest invites.
How excited would you be to have one of these show up at your door?
all images via

AMAZING. So curious about Rebecca Minkoff’s collection now.
Great post!
Those show invitations are STUNNING. I’d loooove to be going, too!
xo Josie
http://www.winksmilestyle.com
it would be a dream to receive that kind of invitation! sigh. one day 🙂 x chelsie (mossypants.com)
i would be beyond ecstatic!! ahh i can’t even imagine how awesome that would be
following you 🙂
The DayLee Journal
Statement Necklace Giveaway
Seeing all of the invites is always so cool…Prabal’s is definitely my favorite!
Alyssa
The Glossy Life
Fabulous in everyway.
oh i want to go!!!!!